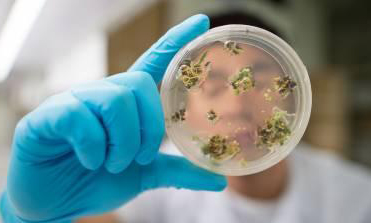

职位推荐
- 珍格医疗-临床销售 15001-20000
- 地奥制药-医药代表 6001-8000
- 普利德医疗-医疗设备销售经理 面议
- 大唐-兼职招商经理 面议
- 景德中药-直营经理 6001-8000
- 安邦医药-省区招商经理 8001-10000
- 恒瑞医药-医药信息沟通专员 6001-8000
- 黄河中药-学术讲师 8001-10000
发布日期:2017-06-13 浏览次数:201
“投早期项目要有充分的心理准备,一定要抱着吃馅饼的愿望和期待,做好跳陷阱的心理准备。”
“从两年前开始,创新药投资迅速由春天进入了盛夏。”君联资本董事总经理蔡大庆说,这个行业太“热”了。
资本市场对创新药如火的热情背后,有着多重投资逻辑:发展生物医药被纳入国家战略、医药产业政策引导、亟待满足的巨大市场需求……
随着资本不断涌入,创新药研发“不差钱”。硬币的另一面是,新药研发成功率不高,产品上市还要应对市场需求考验、招标采购、医保支付准入等问题,这意味着投资的风险很大。
因为大水漫灌,一些创新项目估值水涨船高,出现泡沫化现象。在蔡大庆看来,也需要防范资本潮水一般的涌入可能毁掉国内医药创新之路的风险。
新药风口
近两年,医药创新融资好戏不断,大额案例频频出现。在2016年,至少有38家生物制药企业成功融资。
项目广受追捧,缘于国内创新药行业的重大发展机遇。一方面,快速增长的中国新药研发市场,越来越多富有经验的海归创业,催生了一批充满活力的创新公司。另一方面,自“十一五”重大新药创制专项启动以来,政府不断投入研究经费,支持新药研发,预计2020年药品研发经费投入将达1400亿元,为国内药品创新提供了原动力。
与此同时,围绕鼓励新药研发的多项制度改革也释放了发展红利。监管部门加速创新药审评审批为生物医药领域投资带来机会窗口。2015年以来,在药品审批改革上推出药物临床试验数据自查、严格界定创新药、加速新药审评审批、试点药品上市许可持有人制度并建立医保目录动态调整机制等措施,为技术含量高的创新药及相关研发服务开辟了广阔的市场空间,让致力于创新药研发生产的企业和投资者受到激励。
“2016年贝达药业A股上市之后,近几十倍的回报让人们看到了创新药市场的潜力,也教育了不少投资者。”约印创投CEO郑玉芬告诉《财经国家周刊》记者。
资本热情带动了创新药投资生态圈的建立。不同特点的投资机构,在整个创新药投资链条中扮演着不同的角色。
风险投资是中小型创新药企资金的最重要来源,而其中要求较高投资回报的机构已经意识到,只有在早期介入到创新药项目中,才能实现预期目标。
从药明康德风险投资部门独立出来的毓承资本,一开始就定位专注于生命科学领域早期风险投资,目前管理两支美元基金合计3.5亿美元规模,已累计投资近40家企业,其中包括专注肿瘤细胞免疫疗法开发的Juno公司以及赴美上市的百济神州。
“我们的基金是十年期的,所以可以投较早期的项目。”毓承资本合伙人朱忠远说。
从复星集团出来并于2014年创立景旭创投的钱庭栀认为,早期项目投资是体现投资机构真正价值的所在。
“在我们投资的医疗项目里面,有85%都是属于A轮和Pre-A轮,还有个别的天使轮阶段,只有极少量的是B轮,基本上到了C轮的项目就不再看。”分享投资管理合伙人黄反之说,他们不是去摘果子的,而是去播种、育苗、建生态。
清控银杏创始合伙人薛军认为,选择早期项目投资,除了投资逻辑和风险偏好外,一个很重要的原因是基金规模不大,通过早期投资做出投资组合。
随着众多资本涌入,创新药项目估值日益增高,不少老牌投资机构开始调整策略,在创新药项目初创期就介入。例如,红杉资本就参与了再鼎医药的A轮、B轮融资。
此外,向来“嫌贫爱富”的传统投行也开始寻觅B轮项目。“按照道理来讲,投行是不应该看早期项目的,但中国资本进入行业的速度决定了投行介入时间也有所转变,我们现在不得不从B轮就开始做。”中金成长企业投资银行部负责人王曙光表示。
风口上的挑战
新药研发成为追捧的风口,然而这个风口并不容易捕捉。
随着医疗投资向早期倾斜,许多投资方选择将资本押注在正处于研发阶段的药物上,新药研发就是大浪淘沙的过程,一旦研发失败,投资方大笔资金将血本无归。
“投早期项目要有充分的心理准备,一定要抱着吃馅饼的愿望和期待,做好跳陷阱的心理准备。”对于涌入创新药研发初期的资本,高特佳投资集团主管合伙人胡雪峰这样提醒。
除了创新药研发本身的高失败率,国内投资者还将面临行业政策监管、市场准入及退出风险的考验。
“一些具体政策,包括审批、采购、医保、支付、定价等各环节的变化,都让本土的创新药面临不确定性。”蔡大庆告诉《财经国家周刊》记者。公开消息显示,国内批准的17个创新药中,年销售额超过1亿人民币只有4个。
相较于国外投资环境,国内资本市场的某些局限也引发了新药投资方的担忧。
华盖资本董事长许小林表示,一方面,新药研发项目越到后期,特别是进入到临床试验阶段时所需投资额越大,在企业自主资金不能满足需求时,通过IPO或增发新股是药企筹集资金的重要手段。而目前国内新药研发投资尚未形成全链条的接力棒式资金,在药品研发的前中后期没有形成对应的基金进行全程的投资和扶持,比如很多证券咨询机构和投资公司都没有为药企单独设立多种融资方式,医药行业直接融资比重较低。
另一方面,由于医药产业具有较强专业性,国内创新药价值评估体系尚未完全建立,药企在融资时难以获得令投融资双方满意的价格。也正是因为没有形成完整的投资链与价值评估体系,使得一些投资者不敢在药品研发的前期贸然投资。
“我看过的医药创新项目加起来,即使10%成功,估值差不多能占到5年后国内GDP的10%,有这种可能吗?这里面肯定有陷阱。”蔡大庆说,在创新药价值评估体系缺失的情况下,一些投资人并未看到全局,只是盲目跟风,推高了创新药项目估值。
此外,目前国内资本市场对创新型公司的支持还不够,企业如果要上市,需要有盈利要求。“多数的研发型药企还是没有盈利的,这种情况下国内没有机制让其进入二级市场。”和铂医药CEO王劲松告诉《财经国家周刊》记者,除了鼓励创新药尽快进入临床和市场,政策层面还应考虑对创新投资的回报和价值认可,只有让创新成果更快进入市场,投资机构尽快获得回报,医药产业创新才能形成良性循环。
在多重风险和不确定因素中,坚持全球视野和产融联动是资本界对未来创新药投资认可的逻辑。
胡雪峰告诉记者,基金选择早期项目,应该为产业服务,真正实现早期项目和产业之间的对接。这种早期项目成功率更高一些,或者说有更好的退路。
文章链接:中国制药网http://www.zyzhan.com/news/Detail/65398.html
300多万优质简历
17年行业积淀
2万多家合作名企业
微信扫一扫 使用小程序
